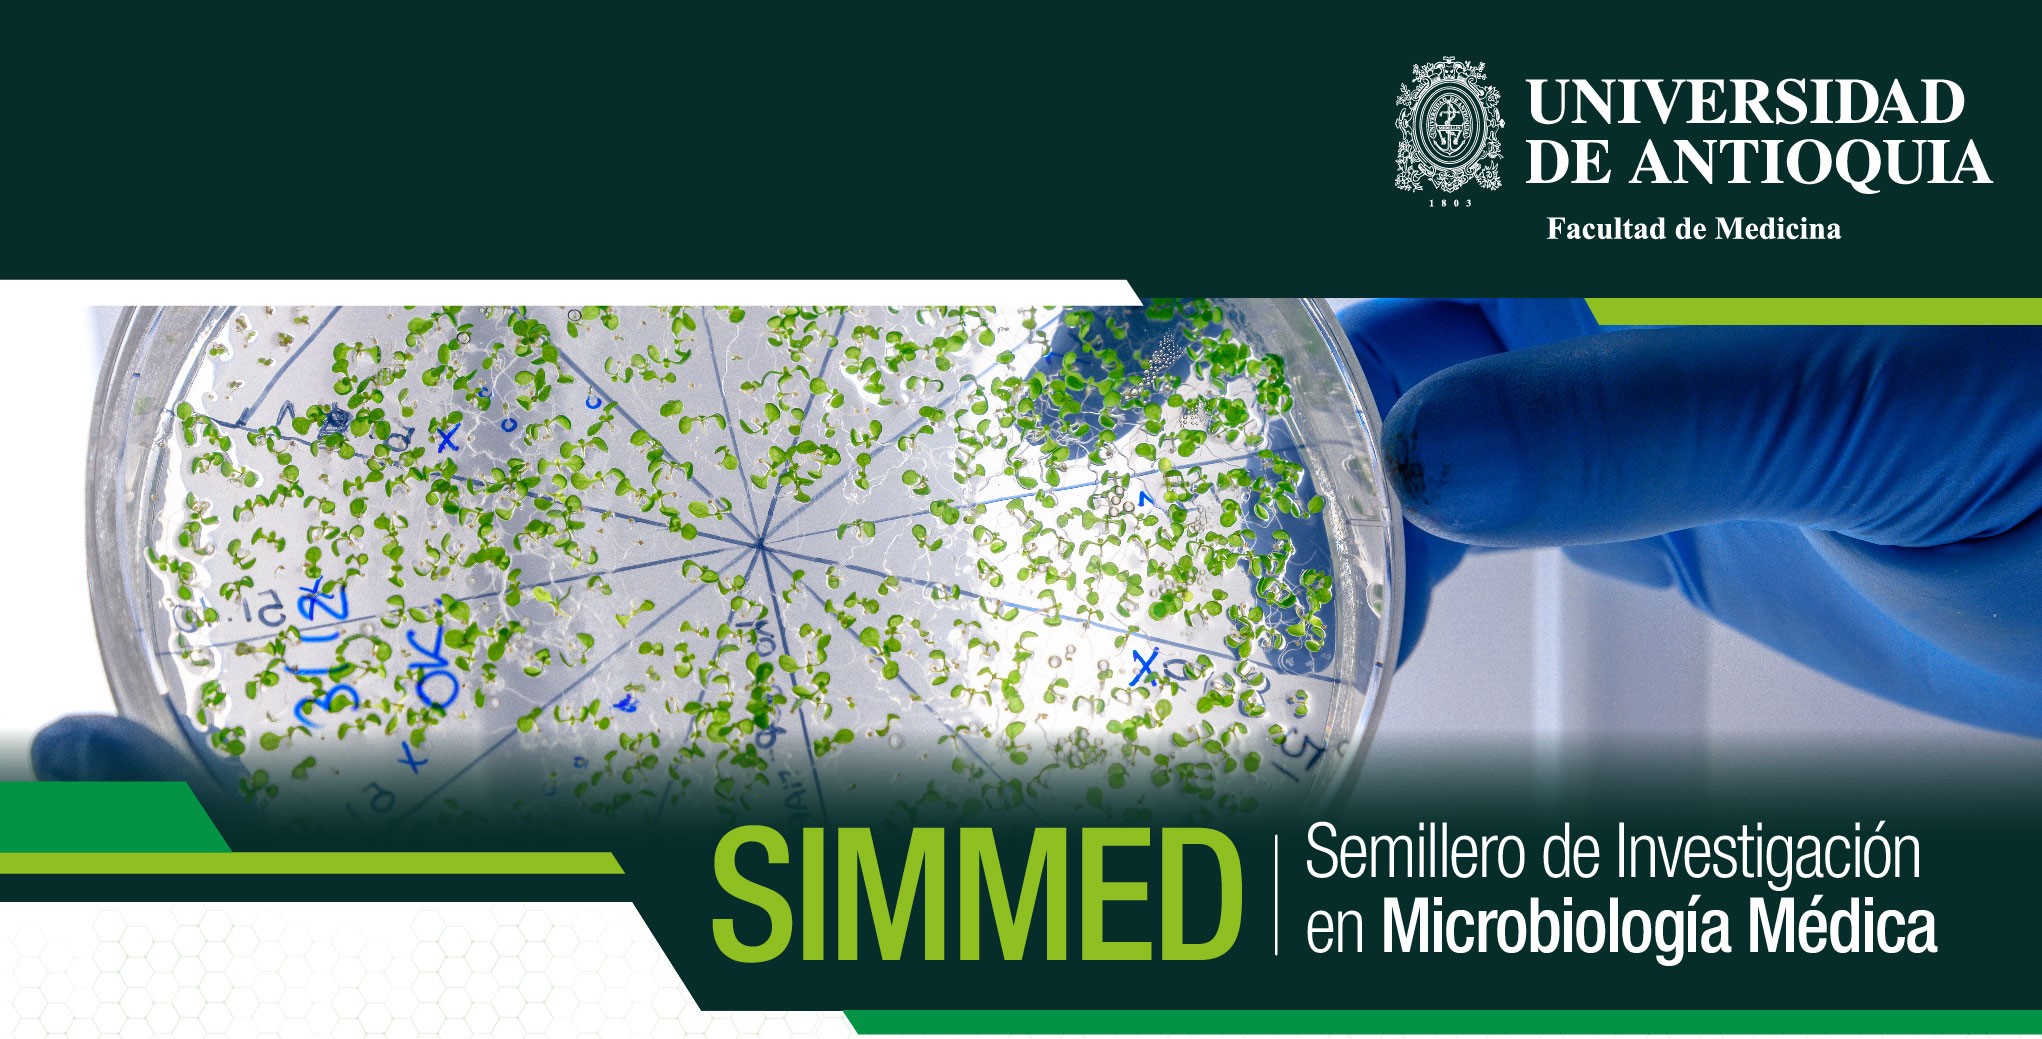

Portal U de A - Cabezote - WCV(JSR 286)
Signpost
Investigación
Portal U de A - Visor de Contenido - WCV(JSR 286)
Portal U de A - Visor de Contenido - WCV(JSR 286)
UdeA - Información Menú - WCV(JSR 286)
Semillero de Investigación en Microbiología Médica e Infectología
El Semillero de Investigación en Microbiología Médica e Infectología, fundado en 2019, es un semillero de investigación conformado por un grupo interdisciplinario de personas, interesados en adquirir y contribuir a la producción de conocimiento en el área de la Microbiología desde el campo de la Medicina humana, como producto de espíritu creativo, pensamiento crítico que promueve el proceso de desarrollo habilidades investigativas y metodologías de investigación idóneos para el análisis, la creación y aplicación de diversos proyectos de investigación e intervención en el área de la microbiología médica.
Misión
Somos un semillero de investigación de la Facultad de Medicina de la Universidad de Antioquia conformado por un grupo interdisciplinario de personas, interesados en adquirir y contribuir a la producción de conocimiento en el área de la Microbiología desde el campo de la Medicina humana, como producto de espíritu creativo, pensamiento crítico que promueve el proceso de desarrollo habilidades investigativas y metodologías de investigación idóneos para el análisis, la creación y aplicación de diversos proyectos de investigación e intervención en el área de la microbiología médica.
Visión
El Semillero de Investigación de Microbiología Médica e Infectología, pretende ser un referente en la realización de proyectos multidisciplinarios e innovadores de investigación e intervención que aporten a la identificación y posible solución de los problemas de salud, vinculando los ejes misionales de la universidad en pro del bienestar y la calidad de vida de la comunidad.
Metodología y actividades
Se realizan reuniones semanales, generalmente los días jueves de 04:00 pm a 5:00 de manera virtual, sin embargo, en caso de ser presenciales, se realizan en la Facultad de Medicina.
Las reuniones son abiertas al público, y durante estas se realizan diversas actividades formativas como:
- Revisión de tema: infectología, microbiología e inmunología.
- Talleres en metodología de investigación.
- Clubes de revista.
- Presentación de casos clínicos.
- Conversatorios sobre historias de vida de profesores, investigadores y egresados
- Experiencias en investigación.
- Presentaciones de tesis y trabajos de grado.
- Presentación de líneas de investigación y proyectos
- Habilidades para la vida.
Aliados
- Departamento de Microbiología y Parasitología de la Facultad de Medicina de la Universidad de Antioquia.
- Grupo Bacterias & Cáncer.
- Micología Médica.
Proceso de vinculación
Para el ingreso al semillero se realiza una convocatoria pública semestral en las diferentes facultades de la Universidad de Antioquia, por diferentes medios de divulgación como: correos y redes sociales. También, participamos de espacios brindados por la facultad de medicina para la exposición de los semilleros de investigación hacia los estudiantes y docentes.
Se explica a los estudiantes que desean participar en qué consiste el semillero, lo que ofrece y qué aportes le brinda a cada uno en su vida personal y académica. Después de la convocatoria, se comienza a asistir a las reuniones programadas para dar cumplimiento a la agenda. Sin embargo, nuestras reuniones son abiertas a todo el público y pueden ingresar sin ser parte activa del semillero.
Datos de contacto
Correo electrónico: semilleroimmed@udea.edu.co
Instagram: @simmed.udea


